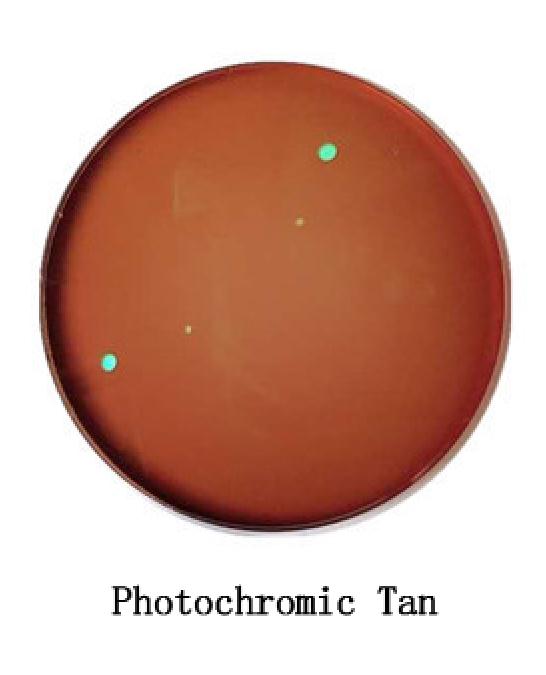
1.56 Photochromic Pink Blue Sunglasses Lens Single Vision Lens 0~-6.0 Myopia Optical Prescription Lenses for Eyewear UV400: Photochromic Tan

- Free shipping
- 100 days returns
- Low prices
- 5 million products
1.56 Photochromic Pink Blue Sunglasses Lens Single Vision Lens 0~-6.0 Myopia Optical Prescription Lenses for Eyewear UV400
Specifications:
- style: photochromic sunglasses lens
- Origin: CN(Origin)
- Gender: WOMEN
- Brand Name: LVCKSK
- 5 Color: Pink,Blue,Purple,Gray,Tan
- Model Number: 75
- Lenses Optical Attribute: UV400
- Lenses Optical Attribute: Photochromic
- Lenses Material: Polycarbonate
- Item Type: Eyewear Accessories
- Gender: Unisex,Men,Women,Boys,Girls
- Eyewear Accessories: Lenses
- Coating: HMC

- Free shipping
- 100 days returns
- Low prices
- 5 million products